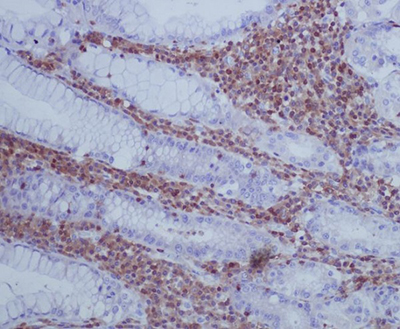
GAP43 Rabbit Polyclonal Antibody | 兔多抗 | EnkiLife恩玑生命

GAP43 Rabbit Polyclonal Antibody | 兔多抗 | EnkiLife恩玑生命
GAP43 Rabbit Polyclonal Antibody
询价
1支
起订
湖北 更新日期:2026-03-23
产品详情:
- 中文名称:
- GAP43兔多抗
- 英文名称:
- GAP43 Rabbit Polyclonal Antibody
- 品牌:
- EnkiLife
- 产地:
- 中国
- 产品类别:
- 抗体
- 是否进口:
- 否
- 用途:
- 科研
公司简介
武汉恩玑生命科技有限公司(EnkiLife)是一家深耕生命科学,专注细胞生物学和免疫学科研试剂的研发、生产与销售的生物技术企业,在全球100多个国家和地区开展业务,致力于为科研工作者提供高质量的产品和卓越的客户服务,推动生命科学的发展。
EnkiLife的产品线涵盖细胞系、原代细胞、细胞培养基、血清、细胞检测试剂盒、重组靶点蛋白、细胞因子、重组抗体、ELISA试剂盒、生化试剂盒等,并提供技术服务与定制开发,覆盖了生命科学研究的各大关键领域,包括细胞生物学、癌症、免疫学、神经科学、心血管疾病、干细胞、表观遗传学、内分泌、蛋白质组学、代谢组学等,全方位满足您的实验需求,让您享受科研的乐趣!
公司现已建立四大技术平台:
EnCyto?细胞培养及检测平台:拥有细胞系库(500+)、原代细胞库(500+)、基础培养基和完全培养基(1200+)
EnkiPro?重组蛋白平台:现货产品2000+,可提供定制化表达服务
EnAb?重组抗体平台:重组兔单抗(3000+),可提供定制化和标记服务
EnKits?试剂盒开发平台:可提供优质的ELISA试剂盒、配套试剂、抗体对、生化试剂盒等相关产品
EnkiLife在生产管理方面引入ISO9001质量管理体系和信息化、自动化的管理工具,拥有高效稳定的交付能力,与全球知名品牌建立了紧密的合作。
EnkiLife始终坚持以技术创新为驱动,以匠心铸就品质,以品质服务客户。
我们期待与更多的全球科研工作者和企业携手合作,共同推动生命科学领域的进步与发展。
| 成立日期 | (2年) |
| 注册资本 | 271万人民币 |
| 员工人数 | 10-50人 |
| 年营业额 | ¥ 100万-300万 |
| 经营模式 | 工厂,试剂,定制,服务 |
| 主营行业 | 生化试剂,抗体,细胞培养,癌症研究,细胞生物学 |
GAP43兔多抗相关厂家报价
-

- LC3B抗体(兔多抗)
- 武汉艾美捷科技有限公司
- 2026-04-05
- ¥3750
-

- IKKα抗体(兔多抗)
- 碧云天生物技术有限公司
- 2026-04-05
- 询价
-

- 兔抗VCAM1多克隆抗体
- 北京百奥莱博科技有限公司
- 2026-04-05
- 询价
-

- GAP43 Rabbit Polyclonal Antibody
- 碧云天生物技术有限公司
- 2026-04-05
- 询价